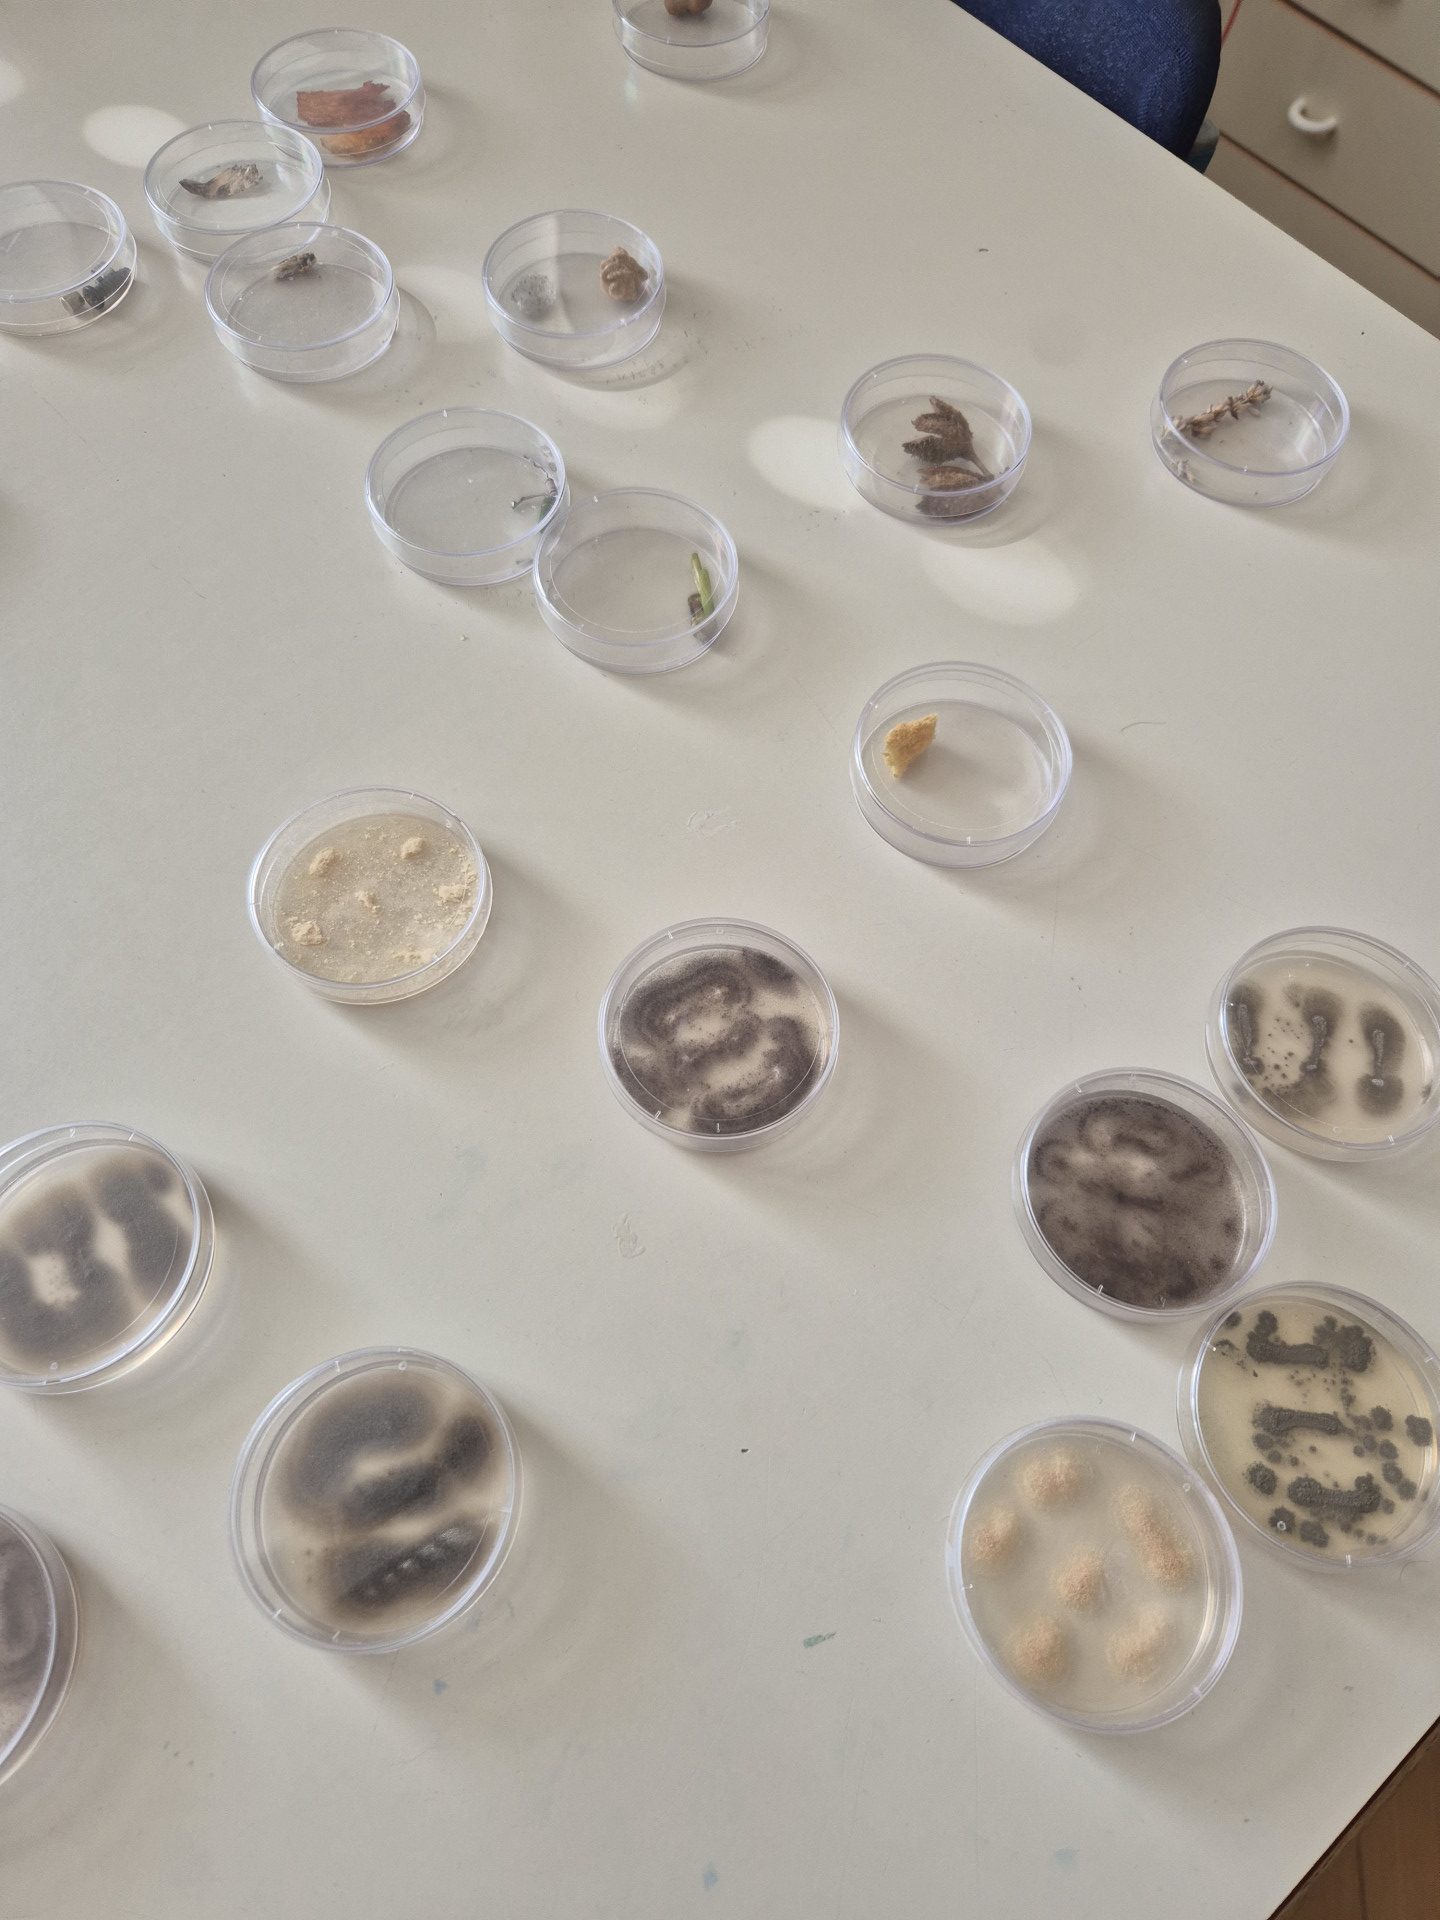

V petek, 27. marca, so učenci 9. razreda imeli izredno zanimiv dan dejavnosti.
O njem sta Tom in Erazem iz 9. c zapisala:
Na današnjem naravoslovnem dnevu smo se naučili veliko novih in hkrati zanimivih stvari s področja mikrobiologije in biotehnologije. Po krajšem uvodnem predavanju smo se lotili prvega eksperimenta s kvasovkami. Po malici smo se preizkusili v vlogi ribosomov pri sestavljanju proteinov. Za dober zaključek smo z mikroskopi opazovali kolonije plesni in bakterijo ter tudi vsakdanje predmete. Naučili smo se veliko novih in predvsem zanimivih stvari. Preživeli smo res super petek.
Fotografije: B. Praznik Lokar in T. Kunaver